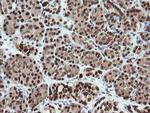
FATE1 Antibody in Immunohistochemistry (Paraffin) (IHC (P))

Search
OriGene
FATE1 Monoclonal Antibody (OTI1A1), TrueMAB™
{{$productOrderCtrl.translations['antibody.pdp.commerceCard.promotion.promotions']}}
{{$productOrderCtrl.translations['antibody.pdp.commerceCard.promotion.viewpromo']}}
{{$productOrderCtrl.translations['antibody.pdp.commerceCard.promotion.promocode']}}: {{promo.promoCode}} {{promo.promoTitle}} {{promo.promoDescription}}. {{$productOrderCtrl.translations['antibody.pdp.commerceCard.promotion.learnmore']}}
产品信息
TA505181
种属反应
宿主/亚型
分类
类型
克隆号
抗原
偶联物
形式
浓度
纯化类型
保存液
内含物
保存条件
运输条件
靶标信息
This gene encodes a cancer-testis antigen that is highly expressed in hepatocellular carcinomas and other tumors and weakly expressed in normal tissues except testis. The protein is strongly expressed in spermatogonia, primary spermatocytes, and Sertoli cells in seminiferous tubules. This protein may have a role in the control of early testicular differentiation and cell proliferation.
仅用于科研。不用于诊断过程。未经明确授权不得转售。
篇参考文献 (0)
生物信息学
蛋白别名: BJ-HCC-2 antigen; Cancer/testis antigen 43; CT43; fetal and adult testis expressed transcript protein; Fetal and adult testis-expressed transcript protein; Tumor antigen BJ-HCC-2
基因别名: CT43; FATE; FATE1
UniProt ID: (Human) Q969F0
Entrez Gene ID: (Human) 89885